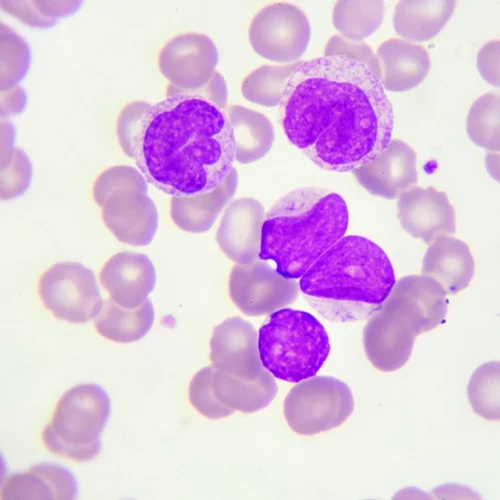
Τι πρέπει να γνωρίζεις για την Χρόνια Λεμφοκυτταρική Λευχαιμία (ΧΛΛ)

ΠΑΣΧΑ ΧΩΡΙΣ ΒΑΡΥΣΤΟΜΑΧΙΑ
Τα 4 όχι και τόσο γνωστά συμπτώματα καρδιακής προσβολής
Τα 4 όχι και τόσο γνωστά συμπτώματα καρδιακής προσβολής. Αναγνώρισέ τα και προστατεύσου.
Οδηγός: Τι φάρμακο να πάρω για κάθε ασθένεια (και πότε ΔΕΝ πρέπει να παίρνεις αντιβιοτικά;)
Η αλόγιστη χρήση των αντιβιοτικών έχει αρνητικό αντίκτυπο στην υγεία μας και κάνει πιο ανθεκτικά επικίνδυνα βακτήρια.
Ο γύρος του κόσμου-ταξίδι με μωρό: Γίνεται και ιδού το πώς!
Ταξίδι με μωρό: Το σκέφτεσαι και σε πιάνει τρέλα; Η madmumtravel, μια δραστήρια νοσηλεύτρια από το Λονδίνο μας «έβαλε» τα γυαλιά και αποκαλύπτει τα μυστικά της.
Shape Tested: Πώς να φτιάξεις τσιπς από λάχανο kale
Τα τσιπς από λάχανο Κέιλ αποτελούν μία ιδανική, υγιεινή επιλογή για σνακ.
Γιατί κολλάς την ίωση του συντρόφου σου (ακόμα και όταν κοιμάσαι στον καναπέ)
Γιατί είναι τόσο εύκολο να κολλήσεις την ίωση του αγαπημένου σου, ακόμα κι αν τηρείς όλες τις προφυλάξεις στην επαφή σας;
Καφεΐνη στην εγκυμοσύνη: Πόση επιτρέπεται τελικά;
Καφεΐνη στην εγκυμοσύνη: Πόση καφεΐνη πρέπει να καταναλώνεις όταν είσαι έγκυος ή για να μείνεις έγκυος; Οι έρευνες «μιλούν».
Τι πρέπει να γνωρίζεις για την Χρόνια Λεμφοκυτταρική Λευχαιμία (ΧΛΛ)
Γιατί καλπάζουν σήμερα τα λεμφώματα και τι πρέπει να γνωρίζεις για τη θεραπεία αιματολογικών ασθενειών όπως η ΧΛΛ (Χρόνια Λεμφοκυτταρική Λευχαιμία).
10 + 1 σημάδια ότι σου λείπει ύπνος (κι αυτό κάνει κακό στην υγεία σου)
Κάθε άνθρωπος έχει διαφορετικές ανάγκες ύπνου. Μήπως όμως κάνεις κακό στην υγεία σου αν δεν κοιμάσαι αρκετά; Μήπως σου λείπει ύπνος σε βαθμό που αρρωσταίνεις;
Γιατί είμαι κουρασμένη; 15 λόγοι που νιώθεις κόπωση και ατονία
Βαρέθηκες να είσαι κουρασμένη όλη την ώρα; Και ναι, μπορεί να σου αρέσει ο ύπνος αλλά δεν είναι δυνατόν να περνάς τη ζωή σου από τον καναπέ στο κρεβάτι.
4 αδυνατιστικά smoothies: φτιάξε ένα κάθε πρωί
Αν ψάχνεις τρόπο να διώξεις τα κιλά, οι χυμοί καθαρισμού ή αποτοξίνωσης μπορεί να μην είναι η καλύτερη ιδέα. Δοκίμασε τα αδυνατιστικά smoothies
Το μυστικό για να χρησιμοποιήσεις την αναβλητικότητα προς όφελός σου
Η αναβλητικότητα περιλαμβάνει ένα σύνθημα, μια ρουτίνα, και μια ανταμοιβή, τονίζει ο συγγραφέας Duhigg. Όμως τι εννοεί και τι μπορείς να κάνεις γι' αυτό;
Καφές στο χωνάκι: Η μανία του #coffeeinacone είναι γεγονός!
Καφές σε χωνάκι ή στη γλώσσα του Instagram #coffeeinacone! Τι συμβαίνει και όλοι πίνουν πλέον τον καφέ τους σε χωνάκι παγωτού;
Παντζάρι το θαυματουργό; Δοκίμασέ το σε ριζότο με αυτήν τη συνταγή!
Μην φοβάσαι το παντζάρι και τις θερμίδες του. Αντίθετα, μπορείς να το δοκιμάσεις σε μια σούπερ συνταγή ριζότο με μόλις 305 θερμίδες.
Η υγιεινή τροφή που δεν περίμενες ότι επηρεάζει αρνητικά το σπέρμα του!
Τα φρούτα και τα λαχανικά αποτελούν βασικό συστατικό κάθε υγιεινής διατροφής, οπότε τα νέα ότι θα μπορούσαν να βλάψουν το σπέρμα ενός άντρα μας σόκαραν.
Ζώδια Οκτώβριος 2016 από τον Κώστα Λεφάκη: Αστρολογικές προβλέψεις για κάθε ζώδιο
Ζώδια Οκτώβριος 2016: Οι προβλέψεις από τον Κώστα Λεφάκη για να μάθεις τι σε περιμένει τον πρώτο μήνα του φθινοπώρου.
Κροκόδειλος: η άσκηση για να ρίξεις την κοιλίτσα
Η ριάλιτι σταρ Millie Mackintosh έχει την δική της αγαπημένη άσκηση για να σμιλεύει την κοιλιά της. Πρόκειται για το push up του κροκόδειλου που μπορείς να πραγματοποιήσεις κι εσύ ακολουθώντας τις οδηγίες στο βίντεο!
Έρευνα: Τι αντίκτυπο έχουν οι διατροφικές διαταραχές στην οικογένεια
Έρευνα SOS μας προειδοποιεί για το σοβαρό αντίκτυπο που έχουν Διατροφικές Διαταραχές των παιδιών στην οικογένεια.
Μάθε πώς θα φτιάξεις το καλύτερο παιδικό δωμάτιο!
Το Maison Madame Figaro Club μας δίνει ραντεβού για να φτιάξουμε το καλύτερο παιδικό δωμάτιο σε ένα ξεχωριστό event.
Το νέο feature στο Facebook για την πρόληψη αυτοκτονιών: «Βοήθησε έναν φίλο που έχει ανάγκη»
Το Facebook λανσάρει τον οδηγό «Βοήθησε έναν φίλο που έχει ανάγκη», με σκοπό την πρόληψη και μείωση των αυτοκτονικών περιστατικών στο διαδίκτυο.
Φτιάξε σπαγγέτι κολοκύθας και 5 ακόμα έξυπνα τρικ για εύκολο αδυνάτισμα
Η διαιτολόγος από το Μανχάταν Sharon Richter μοιράζεται μαζί μας έξι γρήγορα, έξυπνα κόλπα δίαιτας για να μειώσεις τις θερμίδες σου χωρίς στερήσεις.